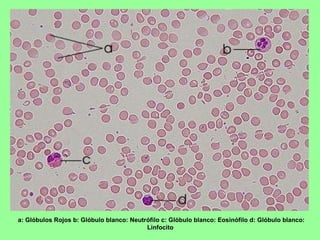
a: Glóbulos Rojos b: Glóbulo blanco: Neutrófilo c: Glóbulo blanco: Eosinófilo d: Glóbulo blanco: Linfocito
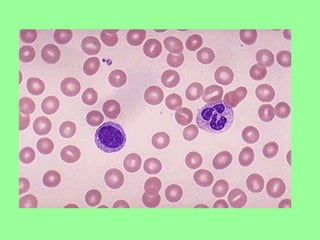
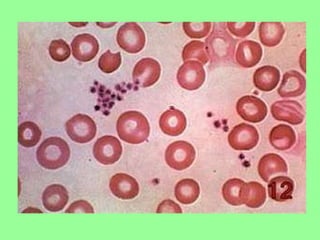

El documento describe el sistema circulatorio humano, incluyendo la sangre, vasos sanguíneos, corazón, sistema linfático y enfermedades relacionadas. Explica que la sangre transporta nutrientes, oxígeno y desechos a través de arterias, capilares y venas. El corazón bombea la sangre a través de dos circuitos. El sistema linfático incluye vasos, ganglios y conductos linfáticos que transportan líquido intersticial y células inmunes.